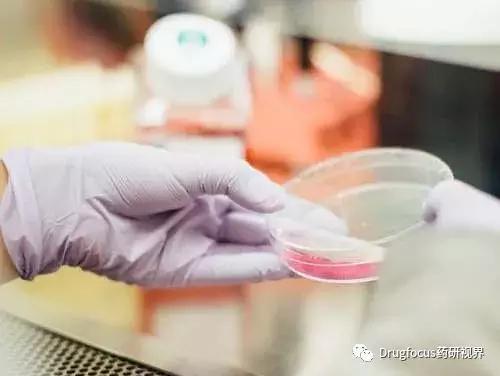
FDA授予I型糖尿病新药teplizumab(RPV-031)突破*药性**物资格

[一周药闻0809]FDA授予I型糖尿病新药teplizumab(RPV-031)突破*药性**物资格
Drugfocus药研视界

药研头条
FDA授予I型糖尿病新药teplizumab(RPV-031)突破*药性**物资格
8月5日,美国Provention Bio公司宣布,FDA已授予该公司开发的单克隆抗体新药teplizumab(RPV-031)突破*药性**物资格(BTD)。RPV-031被用于高危群体预防或延缓发生I型糖尿病(T1D),此次被授予突破*药性**物资格是基于TrialNet开展的“At-Risk”研究的临床数据。该研究评估了teplizumab用于高危群体预防或延缓发生临床1型糖尿病(T1D)的疗效和安全性。研究数据已于今年6月在旧金山举行的美国糖尿病协会(ADA2019)第79届科学会议上公布。
研究结果表明,在高危儿童和成人中,与安慰剂相比,单个14天疗程teplizumab治疗显著延迟了临床T1D的发病和诊断,延迟的中位时间为2年。Teplizumab是第一个可显著延迟T1D临床发病的免疫调节剂,有望干预并从根本上改变高危群体的T1D进展。ADA会上数据发布后,该公司股价飙升355%。
天境生物宣布TJD5在美国完成I期临床首例肿瘤患者给药
8月6日,天境生物科技(上海)有限公司(以下称“天境生物”)与专注于新型肿瘤靶向治疗药物开发及商业化的美国医药公司TRACON Pharmaceuticals(以下称“TRACON”)联合宣布,天境生物自主研发的CD73抗体TJD5(又称TJ004309)在美国完成I期临床试验(NCT03835949)首例晚期实体瘤患者给药。在该项I期临床试验中,TJD5将作为单一用药以及与罗氏销售的PD-L1抗体Tecentriq(atezolizumab)联合用药。天境生物与罗氏于2019年4月达成研究合作协议,根据协议条款,罗氏将向天境生物提供Tecentriq,用于开展与TJD5联合用药相关的临床研究。
TJD5是天境生物自主研发的具有同类最优潜力的新型人源化CD73抗体。2018年11月,TRACON与天境生物达成战略合作,双方共同在美国及其他北美地区进行临床开发。天境生物研发负责人申华琼博士表示:“TJD5是公司自主创新研发管线中第三个在美进入临床研究的候选药物,我们希望通过TJD5和Tecentriq的联合用药可以为肿瘤患者提供创新的治疗方法,以解决未满足的医疗需求。”
国内药闻 TOP3

抗肿瘤单抗市场首破百亿 国内企业挑战罗氏单抗霸主地位
近日,复星医药发布公告称,控股子公司复宏汉霖及汉霖制药研制的用于转移性或复发性实体瘤治疗的新药注射用HLX55(单抗)获得国家药监局临床试验受理,据悉,目前在全球范围内尚无与该新药同类的产品上市。
据米内网数据显示,2018年中国公立医疗机构终端抗肿瘤单抗的市场规模首次突破百亿,是抗肿瘤药9个小类中增速最快的,达到41.36%。其中单克隆抗体的销售额从2013年44.5亿元飙涨至2018年的120.9亿元,增速相当惊人。从品牌格局来看,随着纳武利尤单抗注射液、帕博利珠单抗注射液在2018年获批进口后,中国公立医疗机构终端抗肿瘤单抗市场凑齐了七大品牌。罗氏占了前三位,注射用曲妥珠单抗、利妥昔单抗注射液、贝伐珠单抗注射液2018年合计销售额超过97亿元,跨国巨头罗氏占据中国公立医疗机构终端抗肿瘤单抗的八成市场。
目前正在审评中的国产抗肿瘤单抗新药上市申请有7个受理号,涉及6大产品,其中有两个为生物制品1类新药,4个为生物制品2类新药。其中代表性新药包括:百济神州研发的靶向于PD-1的替雷利珠单抗,恒瑞医药研发的靶向于PD-1的卡瑞利珠单抗,复兴医药的靶向于HER2的曲妥珠单抗,以及齐鲁制药的重组抗VEGF人源化单抗。若上述4个生物制品2类新药也能顺利获批,有望打破罗氏独大的局面,国内抗肿瘤单抗市场将会更加活跃。
迪诺医药提交国内首个TLR8激动剂新药临床申请
近日,上海迪诺医药在国内提交了旗下在研1类化学药物DN1508052-01的新药临床试验申请(IND),已获得CDE受理,系国内提交申请的首个TLR8激动剂。
在体内,Toll样受体(TLR)是参与非特异性免疫的一类重要蛋白质分子,也是连接非特异性免疫和特异性免疫的桥梁。在TLRs家族中,TLR8与自身免疫性疾病密切相关,主要表达于单核细胞、巨噬细胞及髓系树突状细胞,应用前景十分广阔,是肿瘤免疫治疗领域的新星。需要注意的是,TLR8激动剂的毒性是限制其成药的难题之一,目前的研究显示这类药物可能会引发严重的致命细胞因子风暴。针对这种限制,开发新型的低毒TLR8激动剂,有效避免药物毒性,是这类药物未来的开发方向。
上海迪诺医药旗下在研1类新药DN1508052-01是一种高效的小分子TLR8激动剂,拟用于癌症的免疫治疗。
信立泰7大过评品种冲击近200亿市场 4个1类新药如箭在弦
日前,信立泰的抗高血压药奥美沙坦酯片(20mg)获批生产,视同通过一致性评价。作为国内心脑血管龙头企业,信立泰通过创新、首仿或首家通过一致性评价,来形成产品优势互补。据米内网数据,目前信立泰已有7个品种通过一致性评价,其中5个为心脑血管用药;13个品种提交一致性评价补充申请或按新注册分类申报上市,其中3个品种有望首家过评;4个1类新药申报临床,其中2个为心脑血管用药。
7个过评品种中有5个为心脑血管疾病用药,分别为抗血栓药替格瑞洛片、硫酸氢氯吡格雷片,抗高血压药奥美沙坦酯片、盐酸贝那普利片以及降血脂药匹伐他汀钙片。心脑血管疾病用药陆续上市或通过一致性评价,将形成产品优势互补,强化公司在该治疗领域的优势地位。
产品优质创新是信立泰未来发展战略之一,新产品管线的方向是以心脑血管领域为主导,拓展抗肿瘤、降血糖、骨科、抗感染等目标领域,信立泰在研的新药(不包含生物制品)中有4个为1类新药,S086片用于慢性心力衰竭/高血压,目前已进行到临床I期;SAL092片为小分子PCSK9*制剂抑**,该靶点药物自问世至今,颇受业界关注,被誉为是继他汀类药物之后降脂领域的重大进步;注射用信立他赛为抗肿瘤药物,目前已获批临床;苯甲酸复格列汀片为重庆复创独立研究开发的一种DDP*制剂抑**,信立泰以2500万元获得该产品在中国大陆地区内的独家开发和市场权利。
综上,作为国内心脑血管龙头企业,信立泰通过创新、首仿或首家通过一致性评价,来形成产品优势互补,成功摆脱了单一产品依赖的局面。
世界药闻 TOP 3

Sosei Group和Takeda合作开发新分子药物并将其商业化
8月6日,Sosei Group的全资子公司Heptares Therapeutics与Takeda Pharmaceutical签署了一项协议,旨在发现、开发和商业化新分子药物,包括小分子和生物制剂。调节G蛋白偶联受体(GPCR)靶标的分子开发作为战略性多靶标伙伴关系的一部分。根据协议条款,Sosei Heptares以GPCR为重点的基于结构的药物设计能力将与武田的发现、开发和治疗领域专业知识相结合。首先,公司将专注于高优先级的胃肠道领域药物。但是协议包括可能扩展到其他治疗领域。
作为合作伙伴关系的一部分,除了协议期限内的研究经费之外,SoseiHeptares还有资格获得高达2600万美元的前期和近期付款。该公司还有资格获得可能超过12亿美元的未来开发、商业化和基于净销售的里程碑付款。此外,Sosei Heptares将获得由合伙公司产生的Takeda任何许可产品净销售额的分层版税。
赛诺菲的Dupixent在特应性皮炎儿童患者中达到研究终点
8月6日,赛诺菲宣布了Dupixent (dupilumab)在6至11岁患有特应性皮炎的儿童中的三期临床研究取得了阳性结果。结合外用皮质类固醇,这是该适应症的护理标准,该药物在试验中达到主要和次要终末点。
结果显示,根据研究者的全面评估(IGA)评分测量,每4周使用一次Dupixent的患者中的33%、每两周使用一次Dupixent的患者中的30%皮肤清晰或几乎清晰; 这是主要终点,而安慰剂组仅为11%。
此外,每四周给药一次患者中的70%、每两周给药一次患者中的67%,湿疹面积和严重程度指数(EASI-75)的改善率为75%或更高,而安慰剂组仅为27%。
Takeda的vedolizumab SC在日本提交NDA申请
8月8日,武田制药已在日本提交了一项维多利珠单抗(vedolizumab )的皮下(SC)制剂用于治疗中度至重度活动性溃疡性结肠炎(UC)的新药申请(NDA)。该公司建议这种肠道选择性生物制剂vedolizumab SC,可通过注射器或注射笔使用。
Vedolizumab是一种全人源化单克隆抗体,特异性拮抗α4β7整合素,抑制α4β7整合素对肠道黏膜细胞粘附分子MAdCAM-1的结合。MAdCAM-1选择性表达于肠胃血管和淋巴结。本次提交的NDA是基于III期VISIBLE 1临床试验获得的结果。该试验评估了维多珠单抗SC作为维持治疗的有效性和安全性。共有216名患有中度至重度活动性溃疡性结肠炎的成年患者参加了VISIBLE 1试验。在第0周和第2周两次标签开放的静脉内使用维多珠单抗作为诱导治疗后第6周获得临床应答。
UC是一种慢性、复发性的炎性肠道疾病,在日本有超过220,000人受到影响。
在美国和欧盟,vedolizumab于2014年5月获批以品牌名Entyvio上市,用于对常规疗法或一种TNF-α拮抗剂不耐受、或不再响应、或响应不足的中度至重度活动性UC或克罗恩病(Crohn's disease,CD)成人患者的治疗。2018年7月其静脉注射剂在日本获批用于治疗中重度UC。
(部分内容根据网络内容改编,知识产权归该权利人所有,若引用不当或版权争议发生,请相关方及时通知,我方将立即给予删除。)
整理:田田 学海无涯 编辑:绰绰
